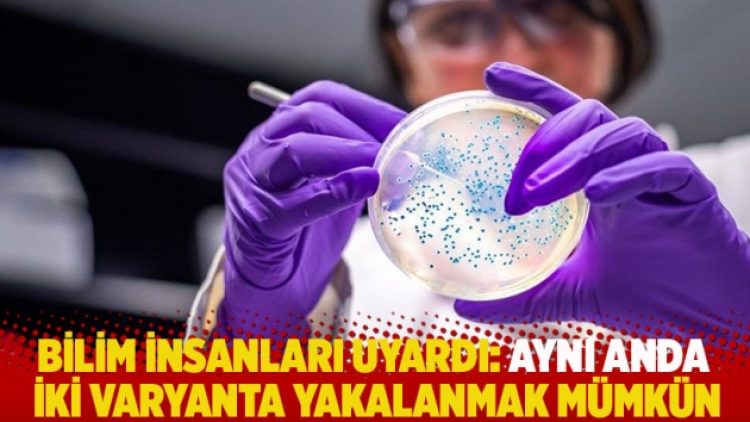
Bilim insanları uyardı: Aynı anda iki varyanta yakalanmak mümkün

Bilim insanları, koronavirüsünün iki varyantına aynı anda yakalanma tehlikesi bulunduğu konusunda uyardı. Uyarı, ‘çift enfeksiyon’ görülen bir hastadan yola çıkarak yapıldı.
Belçika’da yaşayan 90 yaşındaki bir kadın, aynı anda, ilk olarak Britanya’da görülen Alfa ve Güney Afrika’da görülen Beta varyantlarına yakalandı. Mart ayında hayatını kaybeden ve aşı olmadığı belirtilen kadının doktorları, varyantları iki farklı kişiden aldığını düşünüyor.
Hayatını kaybeden kadının, vaka analizini bu yılki Avrupa Klinik Mikrobiyoloji ve Bulaşıcı Hastalıklar Kongresi’nde yapan bilim insanları, iki varyantın da bulaştığı benzer vakalar olduğunun bilindiğini ancak bunun kayda geçen ilk olduğunu belirtti.
Ocak ayında, Brezilya’daki bilim insanları, iki kişinin aynı anda iki varyantı kaptığını, bunlardan birinin Gama olduğunu açıklamıştı. Portekiz’de ise bir Covid-19 enfeksiyonunu atlatmaya çalışan 17 yaşındaki bir kişinin başka bir varyanta yakalandığı duyurulmuştu.
Kongrede, Belçika’da hayatını kaybeden kadının evde birkaç kez düştüğü, hastaneye kaldırıldıktan sonra ise ciddi solunum sıkıntısı çektiği, test sonuçlarının iki farklı varyant sonucunda hastalandığını ortaya çıkardığı belirtildi.
Konu üzerine araçştırma yapan ekibin başındaki, Belçika’daki OLV Hastnesi’nden Dr Anne Vankeerberghen şunları söyledi: “O dönemde bu varyantların ikisi de -Alfa ve Beta- Belçika’da görülüyordu. O nedenle iki ikişiden farklı iki varyant kaptığını düşünüyoruz. Tabii net olarak kimden, nasıl bulaştığını bilmiyoruz. Kadının yalnız yaşadığını ancak bakımına yardımcı olmak amacıyla evine giden kişilerin olduğunu biliyoruz. Durumunun hızlıca kötüleşip hayatını kaybetmesinde iki varyantın da bulaşmasının etkili olup olmadığını söylemek ise zor.”
Dünyada 4 milyonu aşkın can alan virüsün, yeni varyantlarının ortaya çıkması özellikle aşıların etkinliği konusunda endişe uyandırıyor. Son dönemde Delta varyantına yakalananların sayısı artarken varyantlara bir de Lambda eklendi.